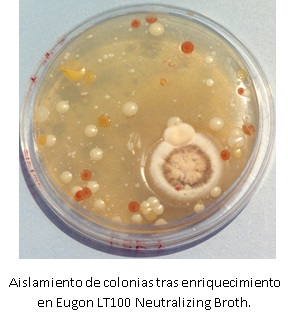
lptagar

EUGON LT100 AGAR es el agar ISO alternativo al TSA en cosmética, tan solo mejorado por LPT Neutralizing Agar (ISO 100.012)
Agar de uso general para muestras con propiedades antimicrobianas, según las nuevas Normas ISO de microbiología cosmética: NF T75-611 (Poder inhibitorio intrínseco), ISO 21149 (recuento de aerobios), ISO18415 (detección de microorganismos), ISO22718 (Staphylococcus aureus), ISO21150 (E.coli), ISO22717 (Pseudomonas aeruginosa), ISO 18416 (Candida albicans).
COMPOSICIÓN
- Triptona 15,0 g
- Peptona de soja 5,0 g
- L-Cystina 0,7 g
- Cloruro Sódico 4,0 g
- Sulfito sódico 0,2 g
- Glucosa 5,5 g
- Lecitina de huevo 1,0 g
- Octoxynol 9 1,0 g
- Agar-agar 15,0 g
(Fórmula por litro) pH final: 7,0 ± 0,2
PREPARACIÓN
Disolver 47,4 gramos en 1 litro de agua bidestilada que contenga 5 ml de polisorbato Tween 80 (SDA071). Agitar calentando hasta ebullición. Autoclavar a 121° C durante 15 minutos. El color final del medio es crema. No sobrecalentar. Agitar hasta su completa solidificación para evitar grumos.
PARA USO EXCLUSIVO EN LABORATORIO. AGITE EL BOTE ANTES DE USAR. MANTENGA EL BOTE BIEN CERRADO EN LUGAR SECO, FRESCO Y OSCURO.
DESHIDRATADO CODIGO: DMT205
CONTROL DE CALIDAD DEL MEDIO:
Realizado en nuestro laboratorio; es prudente repetirlo en su laboratorio siempre que varíen las condiciones (más de 3 meses sin usar, tras desinfectar laboratorio, tras conservar a alta Tª, cuando adquiere aspectos extraños aunque no haya llegado la fecha de caducidad teórica de la etiqueta,…).
DESHIDRATADO: Polvo grueso, Crema
PREPARADO: Estéril, Paja
CONTROL DE CRECIMIENTO CUANTITATIVO 48-72 h a 37°C aproximadamente, o bien 3-5 días a temperatura ambiente (21-28°C aproximadamente):
- Enterococcus faecalis MKTA 29212, Excelente. Con respecto a PCA estandarizado*, recuento 98-220 %. Si se añadió TTC, colonias blancas y medio naranja alrededor.
- Bacillus subtillis MKTA 6633, Excelente Con respecto a PCA estandarizado*, recuento >108-276 %. Si se añadió TTC, colonias anaranjadas o doradas, medio lila alrededor que más tarde vira a naranja.
- E.coli MKTA 25922, Excelente, Colonia amarilla, Viraje amarillo. Con respecto a PCA estandarizado*, recuento 63-127 %. Si se añadió TTC, colonias crema o rojas, medio naranja alrededor.
- Pseudomonas aeruginosa MKTA 9027, Excelente, Colonia amarilla, Viraje amarillo. Con respecto a PCA estandarizado*, recuento 35-122 %. Si se añadió TTC, colonias rojas o doradas, medio lila alrededor.
- Staphylococcus aureus MKTA 6538P, Excelente. Con respecto a PCA estandarizado*, recuento 23-103 %. Si se añadió TTC, colonias anaranjadas, medio naranja alrededor.
- Candida albicans MKTA 10231, Excelente, colonias blancas. Con respecto a TSA estandarizado*, recuento 108 %. Si se añadió TTC, colonias blancas o rosadas.
* El que cumple con recuperación superior al 92-125% con respecto a cepas cuantitativas trazables a la cepa tipo. Incertidumbres detectadas entre todos los lotes a lo largo de un año (la mayoría de la incertidumbre se debe a la cepa y a la proporción de cepas acompañantes inoculadas, no al medio).
PRESENTACIÓN: MEDIO DESHIDRATADO.
SIEMBRA E INTERPRETACIÓN
- Para aislar microorganismos procedentes de productos cosméticos inhibitorios: Repartir 0,1-0,5 ml del caldo Eugon LT100 Neutralizing Broth (MICROKIT ref. DMT204) enriquecido en la superficie de una placa. Esperar que se absorba e incubar invertida a 35°C ± 2,5 °C, durante 48-72 horas. Observar si hay aparición de cualquier colonia e identificarla.
- Para contar aerobios procedentes de productos cosméticos inhibitorios: Sembrar en masa 1 ml de cada dilución decimal realizada en el Neutralizing Diluent SCDLP20 (MICROKIT ref. DMT203). Incubar cada placa invertida a 35°C ± 2,5 °C, durante 72 ± 6 horas.
NOTA: Dados los resultados de los intercomparativos Seilaparfum de microbiología cosmética de los ultimos años, seguiremos recomendando nuestro LPT Neutralizing Agar (DMT066, DMT227, RPL074, TPL0200) y nuestro LPT Neutralizing Broth (DMT217, RPL054, TPL053S), que tan inmejorables resultados proporcionan, aunque nos veamos obligados a fabricar también estos medios Eugon con motivo de las nuevas Normas ISO de microbiología cosmética y la probable ortodoxia que éstas generarán.
https://www.microkit.es/fichas/EUGON-LT100-AGAR.pdf
Solicite la fórmula actualizada (Reach) en microkit@microkit.es
Si desea más información sobre nuestro MEDIO EUGON LT100 AGAR rellene nuestro formulario de contacto http://www.medioscultivo.com/contacto . O si lo prefiere póngase en contacto con nosotros a través de nuestro correo electrónico microkit@microkit.es o por teléfono en el nº 91-897 46 16

